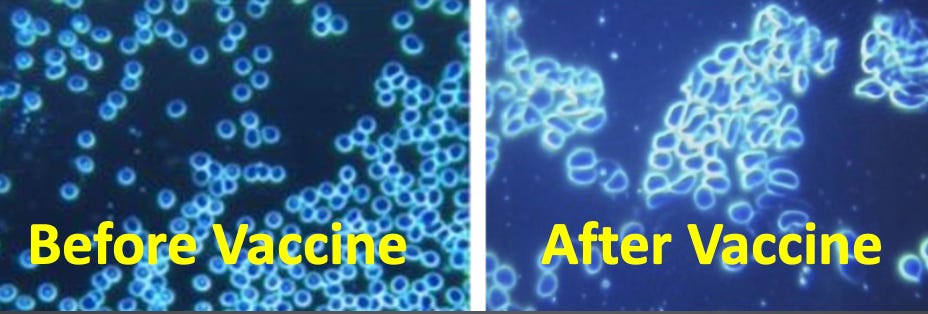

The Real Evidence Behind the Vaccinated Blood Controversies
Critical Thinking in The Age of Censorship Pt. 2: Responding to the "Fact-Checkers"
In today’s article, I will discuss the critical information and logical errors underlying a few of the key COVID-19 controversies. To lay the foundation for doing this, I devoted the first half of this series, to discussing many of the common errors in critical thinking I’ve observed throughout our society, which our academic community has failed to correct and instead has reinforced. These issues are particularly problematic within the medical field, and I would highly recommend reading the first part of this series so you can appreciate the context behind today’s article.
Pseudoscience is a loaded term that is typically used to disparage any type of alternative viewpoint. Because of the inherent uncertainty in what constitutes an objective basis for its definition (as “pseudoscience” typically ends up characterizing whatever happens to challenge the current orthodoxy), a variety of definitions have been proposed. At this point, the most universally agreed upon definition is that any belief which cannot be scientifically disproven (thereby “unfalsifiable”) constitutes pseudoscience, and this a subject I used the questioning of COVID-19’s existence to highlight.
A great challenge with Western Medicine (especially with vaccines), is that it behaves as an unfalsifiable ideology that no amount of failures can disprove. For example, by all objective metrics, the COVID-19 vaccines have failed, and are either useless or have made COVID-19 worse, yet despite this, the majority of elected officials are still insisting the vaccines are essential and many institutions are still mandating them.
Because of this tendency, any time a premise can be established which removes Western Medicine’s culpability for its failures (especially if it argues for doubling down on them), the medical community will eagerly grab onto it. In the case of COVID-19, a frequently cited argument was adopted to defend the vaccines:
•COVID-19 is very dangerous (this is sometimes true, but typically not the case).
•There is no effective therapy for treating COVID-19 (this is not true, but because of its importance in sustaining this argument, a massive campaign of censorship on the early treatments of COVID-19 was enacted to maintain this claim’s veneer of credibility).
•Spike protein vaccines are highly effective for preventing COVID-19 (this is not true).
•The danger of COVID-19 vaccines is minuscule compared to the danger of COVID-19 itself (this is not true).
•Spike protein vaccination also protects those around you from COVID-19 (as detailed in this article and this article, this was a bald-faced lie).
Therefore, if one follows the logical conclusion of this argument, everyone must be continually vaccinated, to the point that it is acceptable to violate the human rights of individuals who erroneously believe the harms of the vaccine are greater than their benefits.
If you look at this argument without recognizing that its premises are false, it is understandable why individuals ascribing to its lies would be such zealous proponents of the vaccines. This argument is particularly challenging because many of the complications of a COVID-19 infection overlap with COVID-19 vaccine injuries (which like many, I believe is a result of both flooding the body with toxic spike proteins), which makes it very easy for those who want to cling onto advocating for the vaccine to do so and find a way to rearrange the “facts” to support their pre-existing biases. Two examples include:
•COVID-19 infection and vaccination can both cause myocarditis. This argument was used to state that the acknowledged risk of “vaccination-preventable” myocarditis outweighed the risk of receiving a vaccine. The problem with this argument is that COVID-19 does NOT increase your risk for myocarditis, whereas spike protein vaccination myocarditis is quite frequent (also see this reference and this reference). Nonetheless, it is still frequently referenced by vaccine advocates to justify vaccination and gaslight those with vaccine induced myocarditis (e.g., one study, which fails to account for the the massive underreporting factor in vaccine injuries, is the most current one being promoted to justify this argument).
•One of the most common adverse reactions from vaccination is the subsequent development of a severe COVID-19 infection (e.g., I know multiple people who were vaccinated and within 1-2 days developed a severe COVID-19 infection, which they died from in the hospital). Instead of being recognized as a vaccine injury, since two weeks are required post-vaccination to be “vaccinated,” these events are typically classified as unvaccinated deaths from COVID-19 and instead used to argue for the necessity of vaccination. Additionally, COVID-19 is one of the most common causes of death linked to the vaccines in VAERS (especially the more time elapses between the time of death and the time of vaccination) and dovetails with the fact that large increases in COVID-19 deaths always follow vaccination programs in a country.
I suspect that this phenomenon occurs because COVID-19 is largely an inflammatory disease, and the immunostimulatory effect of the vaccines alters the immune response so that it attacks the host. I have also reviewed a few reports where someone who knew they were COVID-19 positive (and had minimal symptoms) received a vaccine and then immediately became extremely ill and was hospitalized.
It should also be noted that a similar issue existed with Gardasil, and in its clinical trials, it was found that individuals with a pre-existing Human Papilloma Virus (HPV) infection at the time of vaccination (HPV is linked to cervical cancer due to the chronic inflammation it creates there) caused the previously stable infection to rapidly worsen. Unfortunately, for both HPV and COVID-19, no guidance was ever issued stating that a pre-existing infection needed to be tested for prior to vaccinating, most likely since it was believed this would reduce the all-important vaccination rate.
As you can see from the two above examples, this is a relatively nuanced point, and if one holds onto simplistic truths to defend vaccination, it is very easy to interpret the above in a manner where the logical premises (discussed in part 1) are rearranged so that they argue for vaccination and to attribute the adverse effects of vaccination to being a result of insufficient vaccination.
“Long-Haul COVID”
The above principles are the most consequential for the discussion of long-haul COVID. Briefly, for some people who get COVID-19, after the infection clears, they essentially experience chronic fatigue and a variety of neurological symptoms, many of which are thought to be autoimmune and circulatory in nature.
Many of these symptoms overlap with spike protein vaccine injury, but in most cases are not as severe and respond dramatically better to treatment. For example, I have seen many cases of individuals with long-haul COVID experiencing a complete recovery after a single exosome infusion, whereas, for those with vaccine injuries, the benefit that is experienced tends to be temporary, nowhere near as dramatic, and often requires numerous sessions for a long-term resolution of the vaccine injury (which matters, since these infusions are quite costly).
Long-haul COVID is very much a real thing (e.g., I’ve had a few patients who developed it after COVID-19, long before the vaccines entered the market and if it’s not treated, it has a significant adverse impact on your life). This condition was initially used to market the vaccines (both to prevent you from getting it and to treat it if you had it), and I know many people now where it failed to do either (e.g., a friend and two of my friends’ patients had a partial impairment from long-haul COVID, got the vaccine and then became much less able to function). I believe failures like those I have observed account for why vaccine pushers do not cite this argument as frequently now (the same of which can be said for many other claims that were previously used to market the vaccines).
Many in the medical community have found that one of the best ways to help vaccine-injured individuals to receive support is to reclassify the disease as “long-haul COVID” since this is an “acceptable” diagnosis (it supports the COVID narrative, and unlike vaccine injuries, they can receive financial compensation) that allows the medical community to save face. Because of this, much of the most useful research I have seen on vaccine injuries, including studies of the toxic spike proteins themselves, is always framed under the guise of treating long-haul COVID, (e.g., the primary study used to support my hypothesis on what was causing the blood clots from Died Suddenly), rather than considering the potential mechanisms behind spike protein vaccine injuries.
As a result, we now see ridiculous headlines like this in the news:
Note: One of the earlier articles I wrote on here discussed the large and tremendously costly spike in disability that was seen after the COVID-19 vaccine roll-out, which mirrors the unprecedented spike in deaths also being seen by the life insurance industry. Additionally, as Igor has noted, long-haul COVID-19 is more likely to occur if a COVID-19 infection occurs close to vaccination!
As far as I know, the most definitive proof that COVID-19 vaccinations—and not COVID-19—are responsible for many of the symptoms attributed to them came from autopsies of individuals suspected to have died from vaccination. At this point many studies have detected profound inflammation that likely account for the deaths observed following vaccination. The most recent study, for example, examined 35 individuals who died within 20 days of vaccination. The researchers did a detailed evaluation for any other cause of death and excluded 10 who had potential causes of death besides vaccination. Of the remaining 25, it was determined that 5 died of myocarditis with 3 of those deaths being almost certainly being due to vaccination and 2 others having a likely but not definitive link, while the other 20 had other fatal conditions commonly associated with spike protein vaccination (e.g., heart failure).
To address the question of whether COVID-19 rather that the vaccine could be causing these deaths, the team in Germany that has been spearheading these autopsy studies utilized immunohistochemistry to detect SARS-CoV-2 spike protein (found in both the vaccinated and a COVID-19 infection), and to detect the SARS-CoV-2 nucleocapsid, which is only found in a COVID-19 infection but not after vaccination. As this study shows, only the spike protein—but not the nucleocapsid—was present, demonstrating that the vaccine death cannot be attributed to a COVID-19 infection.
mRNA Persistence
I suspect the primary reasons why vaccine injuries are so much more damaging than long-haul COVID are because:
•Unlike a respiratory infection, the vaccine directly enters the bloodstream, which causes a variety of issues that were detailed here.
•The mRNA persists in the body and continues producing spike proteins long after vaccination.
One of the primary criteria used to approve vaccines is whether they can generate an antibody response (rather than whether they prevent disease, which generating an antibody response is not always sufficient to do). When vaccines fail to elicit this response, they are often modified in an unsafe way (e.g., the HPV vaccine is frequently linked to autoimmunity, and this most likely resulted from a much stronger immune stimulating adjuvant being used in them because traditional ones were ineffective for eliciting a sufficient HPV antibody response).
In the case of the mRNA vaccines, a major problem for the technology was that the body would rapidly degrade the mRNA, and as a result, the mRNA could not manufacture enough of its antigen to elicit an antibody response. To solve this problem, the manufacturers randomly added pseudouridine to the mRNA product, allowing it to resist enzymatic degradation, thereby enabling it to produce a sufficient amount of spike protein to elicit the necessary antibody response.
There were a variety of issues with this approach, one of which was that it is unclear how long the mRNA remains in the body. Since random pseudouridation was the only option available for addressing this problem and the technology had never been trialed in humans before, I am doubtful it was possible to precisely control the half-life of the synthetic mRNA, other than to ensure it was significantly extended. The only study I know of which directly assessed this question found that mRNA was still present 60 days after injection, but the study did not look at the situation beyond the 60 days.
Currently, I know of two other ways to assess this question:
•The first is my own and many others’ clinical observations in the vaccine injured, which suggest that new spike proteins continue to be produced months after vaccination. For example, one patient developed blood clotting after vaccination which persisted for months. At one point in time, my colleague needed to draw blood from him, and was unable to (as the lines kept clotting), even when drawn from one of the largest veins in the body (the jugular vein). This was very unusual (hence why they called me about it), and we later discovered that after months of a customized proteolytic enzyme regimen (which breaks up blood clots) it was eventually possible to draw the blood again. I have also corresponded with other integrative practitioners who have reported similar issues such as needing to pull PICC lines that clotted out in previously vaccinated patients.
•The second way is though autopsies which show that individuals who died from the COVID-19 vaccines had profound autoimmune responses in their tissues (e.g., the heart) months after vaccination. This autoimmune response appears to be a product of cells in those tissues producing spike proteins that coat the membranes of the cells which produced them (thus causing the immune system to attack those cells).
These studies likewise have found the presence of spike proteins in the tissues (e.g., in a death which occurred 4 months after vaccination). Although very few autopsy studies have been done in this area (due to the political risks of challenging the vaccine program), a few brave pathologists in Germany were nonetheless able to compile data to substantiate these claims
Vaccinated Blood
This above slides are from this study of 1006 patients who developed symptoms after spike protein vaccination, of which 948 (94%) had abnormal blood. 12 of those who developed abnormal blood were also examined prior to vaccination.
One of the most common questions I receive: “is vaccinated blood safe?” Many people are extremely concerned about this issue and there is a large demand for unvaccinated blood banks (which some are working to produce).
For example, recently an interesting medical ethics case emerged in New Zealand where the parents of a child who needed heart surgery that would require a blood transfusion during the operation were not willing to have the surgery unless unvaccinated blood was used. Due to the imminent risk of death that the child faced (although months later is still alive), New Zealand’s government has moved to revoke the parents’ guardianship of the child, and transfer it to government authorities so that they can provide the medical consent for his procedure.
The medical ethics behind overriding parental consent to conduct a forced medical procedure is always a challenging question (e.g., I shared a very sad example here). It is particularly interesting in this case because the parents found unvaccinated donors who offered to provide the needed blood, but this request was of course rejected.
When I looked into the basis of the government’s claim that no difference existed between vaccinated and unvaccinated blood, I found that it was predicated on the assertion (for which no evidence was provided) from the New Zealand Blood Service that:
“No, any mRNA from the vaccine that is in the blood is broken down within a few hours after vaccination”
and
“The spike protein is present in vanishingly small quantities in the blood in some people for the first two weeks after their mRNA vaccine. The chance of finding spike protein in donated blood is very small, and it will be in the picogram range if it is there at all. It is not found in the blood after this time period has passed. There is no evidence that this represents any risk to recipients.”
Note: This brief study of 12 vaccinated individuals I believe was the erroneous foundation for the second claim and will be discussed later in this article.
To be completely honest, I have no idea if there is a problem with vaccinated blood, as like many things that should have been tested prior to bringing these products to market, (e.g., the half-life of the synthetic vaccine mRNA), it just has not been tested. At this point, I have seen a few concerning signs suggesting that there are potential issues here, but they are few and far between (which means this issue could either be rare or simply underreported). For example, I have read a few reports of severe reactions to vaccinated blood transfusions, and a close physician colleague had months of issues that were difficult to treat following their receiving a blood transfusion that my colleague was relatively certain came from vaccinated blood (although other factors could also have explained what happened).
The clearest example I know of on this subject comes from a colleague with a patient who refused to vaccinate, required a transfusion for an emergency surgery a year ago (and thus, was unable to exercise their existing desire to refuse vaccinated blood), initially responded well to the surgery, and then after about a week, began to develop the classic profile of a spike protein vaccine injury which has persisted ever since. My colleague was initially skeptical that this could happen, but stated from carefully reviewing the patient’s history, their symptoms and the temporal association between them and the transfusion, my colleague was relatively certain this injury resulted from the transfusion (I likewise agreed with this reasoning).
I have had a long-term policy of following the precautionary principle (which states that no new technology should be adopted until its safety has been proven). There are a variety of opinions on this policy (e.g., some oppose it because it impedes economic progress), but I can personally attest that following it has saved my bacon more times than I can count, after something which was alleged to be safe was later proven to be dangerous.
In certain cases, you don’t really have a choice and need to take a risk, but as best as I can, I try to pre-empt this problem. For example, I knew there would be safety issues with the upcoming vaccines, and prioritized having a method I felt comfortable using to treat COVID-19 before the vaccines entered the market so I would not have to choose between the risks of COVID-19 or its vaccine.
Similarly, if one plans ahead, there are a variety of alternatives to requiring vaccinated blood transfusions. This was an issue I was motivated to investigate once I began learning of all the potential issues with transfusions. Oddly enough much of what I learned came from the fellow Jehovah’s Witnesses of a hospitalized patient I worked with (they’ve studied this issue extensively since their religion forbids blood transfusions, and unlike most religions, is unlikely to be challenged if an exemption is sought since they are always cited as the archetypal example of religious objections to necessary medical procedures).
At this point in time, there is some extremely tentative evidence suggesting that there are safety concerns pertaining to the vaccinated blood supply, but as far as I know, it is all being ignored. The Red Cross, for example, who we trust for our blood supply, just passed the ball to the FDA and deferred to the FDA’s entirely predictable assessment that no safety issues exist. In addition to previous times where our government failed to safeguard the blood supply (some of which are detailed by Ryan Cole here; one of the most famous examples was a famous athlete who later died of AIDS contracting HIV from a blood transfusion during an open heart surgery), Judy Mikovits has also noted that when she tried to alert the H.H.S. to contamination issues she discovered in the blood supply that needed to addressed, her findings were also ignored.
Since the time I initially wrote this article, despite frequent protests outside the courtroom, the New Zealand government did rule in favor of mandating that the child receive transfusions of vaccinated blood. I would like to cite a few quotations from an article on that decision:
New Zealand’s health authorities and blood service argued that allowing the parents to refuse vaccinated blood would set a dangerous precedent, in which patients could demand to pick and choose where their blood came from.
Vaccines to prevent severe disease and death from Covid-19 have been found to be extremely safe and effective, with millions of people around the world vaccinated.
The judge noted that New Zealand’s blood service had presented evidence from the past six months of a “significant increase in potential blood recipients asking for blood from unvaccinated donors or asking about directed donation. Similar trends have been noted in other countries.”
The case was filed by the Auckland health service Te Whatu Ora. In a statement last week, interim director Dr Mike Shepherd said: “The decision to make an application to the court is always made with the best interests of the child in mind.”
It goes without saying that if the health service’s primary goal was the child’s best interests, it would have been possible for the authorities to have worked with the parents and come to a compromise that all parties could agree upon rather than using the strength of the state to force the parents to comply (I am opposed to this approach). They also would not have needed to go through the cost of a court case and would have been able to initiate the operation much sooner. Steve Kirsch recently provided a much more detailed account of the ruling and highlighted a few of the most important details for those who wish to learn more.
Note: I am also frequently asked if it is safe to have sexual relations with vaccinated partners, and I have no idea what to say here since both me and my spouse are unvaccinated. I have seen online accounts of ultra-sensitive patients (who I periodically work with, so I can appreciate their unique sensitivities to things we would typically not consider to be problematic) state that they cannot tolerate being around vaccinated individuals, and I could see this issue also extending to sexual relations.
I have also met approximately a dozen women who developed menstrual issues they sincerely believed came from being around vaccinated individuals (a few cases had very strong temporal correlations, particularly if the vaccinated individual had recently been vaccinated, the rest were much more speculative). I also know a few massage therapists and acupuncturists who have told me they develop symptoms when treating vaccinated individuals, and I have one patient who is a sensitive healthcare worker that eventually realized being around vaccinated people caused significant menstrual abnormalities for her and cannot be treated by vaccinated individuals. Laura Kragie M.D. has also made similar observations.
Currently, I only know of one example where I believe a complication appeared to have occurred and I knew the affected individual personally. A physician colleague who had avoided being vaccinated (but was frequently in close contact with vaccinated patients) asked her partner to avoid vaccinating, but he ignored her advice and got vaccinated without telling her. They had intercourse later in the day, and since that time my friend has had irregular menstruation (but no other issues), which she attributes to that event. If this “shedding” does in fact occur, my best guess is that it occurs from the exhalation of spike protein coated exosomes.
Fact-Checking
I appreciate the fact-checkers for three reasons. The first is that they keep me on my toes (being continually intellectually challenged is one of the many things which helps prevent Alzheimer's disease). The second is that they often inadvertently promote my work. The third, and most important, is that they help me know if my argument is on target or has real issues that need to be addressed. I always question and attack each idea I consider putting forward (leading to many remaining unpublished), but my ability to do that is understandably limited. An outside party doing the same thing is often immensely helpful and saves me a lot of time.
Sometimes however, the fact-checks that I see are just not that good. For example, in my first article here, I argued that, like COVID-19, the early smallpox vaccines worsened rather than improved smallpox epidemics. This then created a downward spiral as panicked governments responded to increasing smallpox cases by more and more aggressively mandating smallpox vaccinations (which was necessary as the public became aware of the severe side effects from the vaccinations, and revolted against the mandates).
A massive protest eventually broke out in Leicester (an English city), resulting in mandatory vaccination being scrapped and replaced with quarantining sick patients and their contacts alongside improved public health measures. Apocalyptic predictions were made for Leicester by the medical community, but the city instead had a remarkably low smallpox incidence, and because of its success, their method was subsequently utilized around the world to end smallpox.
This fact check labeled my claim as false and cited the following reasons:
However, available literature has shown that the Leicester Methods was formed by people who believed in the vaccination but recognised its limitations within a community.
You often see fact-checking statements like this which appear to disprove the central claim but in reality are irrelevant (the fact checker never attempted to disprove my central arguments). I affirmed the above statement in my essay as the local government was forced to adopt this approach after the population became unwilling to continue mandatory vaccination and used their protest to force a policy change.
The National Institute of Allergy and Infectious Diseases website has shown that vaccination was essential to eradicate smallpox.
The NIAID is the division of the Federal government run by Anthony Fauci, and somewhat understandably, like the CDC, will always claim vaccines were the greatest thing since sliced bread because their entire agency depends upon upholding this mythology. The specific evidence the NIAID provided that supports the fact-checker's argument consisted of: “Through vaccination, the disease was eradicated in 1980,” which does not prove anything other than an authoritative source stating as such.
Moreover, the Center for Global Development website has again confirmed the same.
I felt that this source provided the strongest arguments to support the fact-checker. It briefly described how aggressive quarantining was done in conjunction with targeted vaccination to suppress smallpox. It was possible to eliminate smallpox according to this article because:
•It had no animal reservoir.
•Infections were easy to recognize early in the disease process.
•It was relatively non-contagious. This is why monkey-pox never became a thing, whereas in contrast, no amount of quarantining, including China’s imposing a draconian police state upon its citizens, which threatened its governmental stability and China, of all places, was eventually forced to back down from, could contain COVID-19).
•Vaccines and natural immunity provided permanent immunity to smallpox. I know—at least for the original smallpox vaccines—that this was a false statement, because a major reason for vaccine refusal was that many vaccinated individuals subsequently died from smallpox. Similarly, documentation exists at the time showing that the early hospitals and their physicians were covering this up to protect the vaccination program (the mass formation behind the current pandemic has been festering for a very long time).
Except for the last argument, I agreed with these points, but do not believe they prove the smallpox vaccine cured smallpox, as quarantining was most likely the key factor that controlled smallpox due to the infection being uniquely suited for this approach. Keep in mind that while we now take this approach as being self-evident, at the time much was still not known in medicine and quarantining was a new innovation.
From the available literature, it seems that quarantine measures, well-established before vaccination, played their part but could not have achieved eradication alone.
Interestingly, the fact checker concluded the article by acknowledging to some extent my previously labeled-as-false claim was, in fact, true. It should also be noted that although the concluding premise was asserted, nothing was ever done to substantiate that vaccination was necessary for the elimination of smallpox. Equally, my entire article discussed the original smallpox vaccine, whereas a freeze-dried formulation was utilized in the later elimination campaigns, which may have had a different effect on the recipients (many different smallpox vaccines with varying safety profiles have been developed since Jenner’s time).
Dr. Burnett
Dr. Burnett inspired the previous article I wrote on Died Suddenly with this sassy Tik-Tok critique he posted of Died Suddenly. Due to his tone, he ruffled a lot of feathers in the vaccine safety community, but I felt he did make a few valid points that needed to be discussed. It should also be noted that Chris Martenson recently published a video on those clots that effectively debunked many of Dr. Burnett’s points (along with the views of a few other other fact-checkers), and discussed the model I put forward:
Following the publication of the above article, Dr. Burnett was kind enough to share my article in his critique of it. After it was tweeted, Pierre Kory informed me via email that:
This thread is insane. It reminds me of the threads I’ve had to read trying to debunk ivermectin. It's so easy nowadays to sound somewhat smart and evidence-based while making all these pseudo-intellectual debunking claims.
I thought this over, agreed with Dr. Kory’s assessment, and realized that Dr. Burnett was providing an invaluable service for highlighting critical thinking and the cognitive errors described in this series. Additionally, I felt that since my hypothesis had been seen by so many people, I was obligated to defend it. With that in mind, let’s get to Dr. Burnett’s critique!
Nothing to say here except that I suspect members of our community got under Dr. Burnett’s skin by sending my article back to him.
I have no disagreement with this because he is accurately representing my position, so I am not sure if this debunks any aspect of my article. Sadly the screen-shotted video no longer exists because it attracted too much attention and my channel, which I spent the last year compiling was deleted by Vimeo (it is being gradually re-uploaded elsewhere).
My reason for citing the article was because it had the only semi-detailed summary I had come across for describing their composition (as no one else wants to publish them) and thus, it had some clues we could consider to try to elucidate what was causing the clots. I am therefore not sure if this is the most appropriate approach to take to debunking my article. However, the common way that mentally lazy people debunk opposing claims is by attacking the messenger rather than the message, as it gives them a way to quickly sound smart and authoritative without needing to make the effort to understand an opposing viewpoint (as discussed in part 1). As a result, this type of debunking is irresistible, although I feel that overtly slandering The Epoch Times as a “rag” weakens, rather than strengthens Dr. Burnett’s credibility.
This is correct, and the reason why I did not heavily emphasize the article. Something I do not believe Dr. Burnett appreciates is that like other aspects of the pandemic, many laboratory owners have been asked to test the blood clots, but have been unwilling to publicize their data for fear of their lab going out of business in retaliation for doing so (I know specific instances of lab owners who stated this).
In effect, this situation is not that different from the embalmers who have reported to me and my readers that they are observing these clots but are afraid to speak publicly on this issue. As far as I know, Mike Adams is the only person who has published laboratory findings on the composition of these clots, which is because he created a lab for the purpose of doing controversial analyses. For this reason, the data on the clot composition is quite preliminary, which again speaks to why I referenced the article in the manner I did.
Note: A sizeable portion of Burnett’s critique was directed towards debunking the Epoch Times article, so for length considerations, I will move to the next section of his critique
This is an accurate portrayal of my position and bears special consideration because this paper is a pivotal component of the model I am putting forward. I do not, however, agree with Dr. Burnett’s refutation of my assessment of the paper. To substantiate his critiques, Dr. Burnett cites this fact check which is 17 months old.
Like many fact checks, this article repeatedly insists there is no evidence of viewpoints contradicting the orthodox position, even though there are. In fairness, many of those studies were published after the publication of this fact check, but that does not remove Dr. Burnett’s culpability for choosing to cite the outdated article as his evidence to refute my hypothesis (which I believe came about from him reaching for something he could quickly cite to prove his point rather than an attempt to fully understand the subject). For example, this fact-check devoted a significant focus to attacking Bryan Bridle while neglecting to mention a later study that clearly supported Bridle’s position (Bridle provides a detailed summary here).
The most important study referenced in my article was then discussed by Burnett.
I believe these two posts highlight our central disagreement. The vaccines were sold to the public as being “safe” due to this modification, and hence, created a simplistic truth to frame the debate around the vaccines being infallible.
Note: a lot of pharmaceutical marketing revolves around having PR firms establish similar frameworks so that physicians, who typically do not question their premises, will believe that they are being excellent doctors by pushing the current product on their patients.
This "safe" spike protein argument should raise some clear red flags, as many have become extremely ill from these experimental proteins.
To make this argument, the following is assumed:
•This modification was sufficient to prevent the spike protein’s characteristic interaction with the ACE2 receptor and is consistently present in all synthetic mRNA produced.
I have seen a lot of things suggesting otherwise, but I will give Burnett the benefit of the doubt here.
•The only way spike proteins can enter or affect endothelial cells is through the spike protein’s characteristic interaction with the ACE2 receptor.
There are a variety of other mechanisms as well. For example, the endothelium is the first tissue that will take up the vaccine (as because it lines the blood vessels) and the lipid nanoparticle entry of the mRNA into the cell is independent of the ACE2 receptor (at which point, the spike protein is then produced within the endothelial cells and then expressed on their surface, provoking a severe and documented autoimmune response that damages the endothelium). Similarly, the positive electrical charge of the spike protein—receptor binding region directly attracts it to negatively-charged regions of the body (e.g., I believe this is how it can “do the impossible” and enter the nucleus). The endothelium, due to the glycocalyx, also contains a strong negative charge.
•Most importantly, this argument assumes that the only mechanism of spike protein toxicity is its interaction with the ACE2 receptor.
This ignores many of the other potential toxicities of the spike protein such as:
-It is able to bind heparin (which coats the protective layer of the endothelium) and then activate the alternative complement pathway on cell surfaces (the compliment pathway also induces blood clotting, due to the sudden need to address this problem, drugs are now being studied for addressing it). I was alerted to this issue by colleagues who work as consultants and knowing my interest in vaccine toxicity, they informed me that inhibitors for this process have recently become a research focus within the pharmaceutical industry.
-It is highly inflammatory.
-It pathologically alters other components of the clotting cascade.
-It has a prion-forming domain.
-It has a positive charge, which I have argued impairs the physiologic zeta potential and leads to catastrophic consequences. Shortly after I had published that article, I was alerted by a reader to a preprint released last week, which provides a great deal of additional evidence that the SARS-CoV-2 spike protein causes blood agglutination clumping due to how its charges effect zeta potential. This fact may account for many of the adverse events experienced by some after vaccination (the paper will be discussed in more detail next week).
-It has homologies to a variety of tissues that appear to frequently provoke autoimmune disorders (autoimmunity is one of the most commonly observed side effects of the spike protein vaccines). One of these disorders, anti-phospholipid syndrome, which typically develops in 0.0487%-0.0649% of people each year, dramatically increases one’s likelihood of severe blood clots, infertility (e.g. by impairing the blood supply to the placenta), and death. This review paper extensively discusses the many mechanistic links between APS, COVID vaccination, and blood clotting (e.g., extracellular RNA can trigger the coagulation cascade)
Note: One rheumatologist I have corresponded with has told me that when testing for APS via the fairly affordable AVISE test, they observed many patients with a previously negative test develop APS shortly after mRNA vaccination. Presently they find 30-40% of those screened to determine their risk for receiving a booster are lightly positive (while 1.5-2% are strongly positive). They also suspect some of those results came from a previous COVID-19 infection (which due to Omicron almost everyone has had now) as one study found APS in 40-52% (depending on what cut-off was used) of patients who were hospitalized for COVID-19. However, since follow-up was not part of the study, it was not possible to determine if APS persisted in those patients.
Because of all of this, my colleague suspects APS is a key reason why the vaccines are killing people. Unfortunately, APS is a relatively difficult disease to treat so protocols for it are still being developed. My colleague presently suggests aspirin to anyone who is positive for one antibody, and more aggressive anticoagulation (Xarelto can help, Eliquis seems to be better, Warfarin appears to work best but has a variety of issues with its usage) for those with multiple positive antibodies and as needed for those with a temporary higher risk of blood clots (e.g. flying on a plane).
Additionally, this rheumatologist has also found the PULS test, which measures a variety of inflammatory markers, is one of the most accurate for predicting one’s risk of an acute coronary syndrome (e.g. a heart attack in 5 years). They then referred me to a study of 566 patients who had an average risk of 11% prior to vaccination and 25% following vaccination.
In short, Burnett does an excellent job of illustrating why asserting a simplistic truth can provide the appearance of expertise, but in reality, completely fails to elucidate a complex subject.
The basis for this claim is a single study of 12 participants, where the spike proteins in their blood following vaccination was measured. The spike proteins were observed to go up, peak at 5 days, and then decline. In addition to the small sample size, there are three major issues with assuming this study’s results can generalize to everything else.
The first is that no industry study has ever been performed to assess how long the spike protein mRNA persists in the body, despite this being a standard requirement for each new drug. This has been admitted in the publicly released regulatory documents on Pfizer’s vaccine (skip to Pharmacokinetics). Lipid nanoparticles containing a light-producing protein (luciferase) have been used to assess the distribution of the vaccine in rats, but to the best of my knowledge, no studies exist where pseudouridation was used to prevent degradation of the luciferase producing mRNA (so it likely will not be metabolized in the same manner as the vaccine spike protein mRNA).
The second is that this claim ignores a study finding vaccine mRNA and spike proteins in the lymph node germinal centers for at least 60 days after vaccination (figure 7B on page 12 clearly shows this and suggests that the spike protein will persevere for much longer). To my knowledge, this is the only publicly available study that has investigated this question, which is quite frankly, obscene, as the manufactures should have been required to produce that data before their products were mandated on the population.
The third is that it ignores the autopsy findings demonstrating that spike proteins that did not arise from a natural infection are present in vaccine recipients long after their deaths.
As far as I know, only one other study has assessed the persistence of spike protein in the blood. The key datapoint from that study was this graph:
From this graph, it should be evident that the spike protein does not stop being produced at at least 70 days post vaccination. The authors of this study also noted that “our results are consistent with spike-specific antibodies blocking the detection of the antigen in antigen capture-based assays,” indicating that they were likely undercounting the amount of spike protein present (this also likely applies to the Simoa Assay used in the study Dr. Burnett cites). This suggests that some degree of the decline in spike protein presence in the blood analyzed in the study was not actually occurring (which is also consistent with the second vaccination creating a much smaller increase in circulating spike protein).
Based on all of this, I suspect that if spike protein production were to be properly monitored over 6 months, the trend would differ from the purported brief spike and then permanent disappearance (and may spend part of that time period in regions of the body besides the bloodstream). However, as stated before, no testing of the sort was ever (publicly) done before the largest forced experiment in human history was conducted.
A minor point to mention here is that in the pivotal study I referenced in the previous article, the authors tested 100,000 pg/mL, 50,000 pg/mL, 10,000 pg/mL, and 1000 pg/mL concentrations of the spike protein. 1000 pg/mL was sufficient to cause a significant occurrence of these misfolded fibrin clots, and no lower concentration was tested. It is thus quite possible that a lower concentration approaching the 68 pg/mL level would also be sufficient to have some degree of effect on fibrin clot formation.
This perfectly demonstrates the unfalsifiability of Western Medicine discussed above.
Here, Burnett is referencing the study I cited, which to my knowledge, is the only article which evaluates how long the mRNA persists in the body.
Burnett’s refutation of this article has two central issues:
•It was cited to demonstrate that mRNA does not disappear within hours as claimed by the authorities. His critique does not in any way disprove this response.
•You cannot state that this is a perfectly normal response to a vaccine because there is no past precedent for the behavior of an mRNA vaccine or what constitutes a “perfectly normal immune response” to pseudouridated mRNA.
When I read this, I felt that this was the strongest argument Burnett raises to refute my hypothesis so I heavily considered his critique into consideration and spent a long time looking into it.
To address his first point, I believe the reason why 20 out of 26 of Montagnier’s cases were seen in France was that Luc Montagnier is one of the only researchers alive who would be willing to publish research like this which exposed him to such significant professional risk. Given that I had never heard of anyone discussing someone developing CJD before the COVID-19 vaccines, and I now know of three people, I am somewhat inclined to believe an increase has occurred.
Note: As shown above, Burnett stated 26/26 occurred in France which suggests he did not read the paper he “debunked.” This sadly is something you commonly observe in the pseudo-intellectual community as their focus lies upon being right rather than understanding an opposing viewpoint.
In regards to the databases in question, if we were to assume that my assessment of an increase in CJD was valid (it could also, as Burnett asserts, just be wrong), I can see two explanations for the discrepancy. It could either be an issue of under-reporting (e.g. researchers were afraid or unwilling to report it) or not enough time has elapsed to observe this (e.g., the CDC’s data only goes back to 2020 and Europe’s global CJD surveillance network, which tracks 29 countries, also only goes back to 2020). At this point, the only dataset I’ve been able to find which includes the years where vaccines have been on the market is Canada’s (which does support Burnett’s assertion that no increase is occurring), so I am unsure how they were able to claim an increase is being observed following vaccination as the data does not appear to exist.
When I read the fact-check that Burnett cited, I realized that many of the necessary references were missing (hence, why I had to look for the databases myself), and it instead defaulted to common tropes like “The CDC, and certainly the British who have very rigorous vaccination surveillance systems have not found an increase in Creutzfeldt-Jakob disease,” and “correlation is not causation” for the case reports (which I believe is tenuous to argue given just how incredibly rare CJD is). They also, of course, emphasized that “none of these articles were peer-reviewed” (which at this point primarily functions to prevent controversial hypotheses from being discussed).
I then did a quick look on open VAERS (search for “Creutzfeldt”) and discovered from 1990-2020, a total of 12 cases of CJD had been reported, most of which did not have causation asserted by the reporter, whereas in 2021, 33 cases were reported, and 40 have thus far been reported in 2022. Of these 73 cases, most noted a temporal correlation suggesting CJD resulted from the vaccine, and 72 were listed as being from a COVID-19 vaccine, while one was listed as unknown (but had a Pfizer COVID-19 lot number).
It is well known that most vaccine injuries go underreported (98-99% depending on the estimate). In many of the CJD cases, despite the immediate temporal correlation, the reporting physician strongly disagreed with the relative insisting on this link, and said that it was impossible for the vaccine to be linked to CJD. This leads me to suspect that significant underreporting was also present here, especially for cases that occurred when more time had elapse since vaccination and were thus harder to link to vaccination.
Interestingly, many of these cases came from France (on that note, VAERS stopped allowing free text to be entered in VAERS reports from Europe last month). To specifically address Dr. Burnett’s concerns, I suspect that this was due to Montagnier’s work making some of the French become more open to reporting these occurrences, and the French Children’s Health Defense patient network being available to bring vaccine CJD cases to Montagnier’s attention. Additionally, the French have a culture which is more open to challenging certain medical orthodoxies (e.g., they were the only country to advise against using ibuprofen for COVID-19 something I also concluded from my own observations of the disease).
Most of the VAERS CJD cases occurred within a few days of receiving a vaccine (for the 51 where time since vaccination was known, I calculated an average of 43 days, 19 if the longest 10% were removed, and 7.6 if the longest 25% were removed). These results were in accordance with Montagnier’s findings:
In a few weeks, more 50 cases of almost spontaneous emergence of Creutzfeldt-Jakob disease have appeared in France and Europe very soon after the injection of the first or second dose of Pfizer, Moderna or AstraZeneka vaccines. To summarize, of the 26 cases analyzed, the first symptoms of CJD appeared on average 11.38 days after the injection of the COVID-19 "vaccine". Of these 26 cases [I could only identify 3 that were also reported to VAERS], 20 had died at the time of writing this article while 6 were still alive. The 20 deaths occurred only 4.76 months after the injection. Among them, 8 of them lead to a sudden death (2.5 months). All this confirms the radically different nature of this new form of CJD, whereas the classic form requires several decades.
Given this development, I am unsure if the fact-checkers’ statement regarding the rigorous monitoring for safety signals is entirely accurate, as between 0-1 cases of CJD should have emerged in VAERS but instead 73 did. Remember, only one in a million people are supposed to develop CJD per year (or one in 32 million over 11.38 days).
This was the part of Burnett’s fact check that I most disagreed with, as he effectively stated “instead of making the effort to review Fleming’s case, I am going to attack his character so I can maintain a veneer of authority here without having to make the effort to understand Fleming’s claims.” In some cases, if you do this, it doesn’t really matter because the evidence being provided is of poor quality; however, since Fleming produced a very compelling body of evidence to support his argument, I believe that Burnett is at fault for taking the intellectually lazy path here.
Outside of that, this issue touches upon two larger issues. The first is that selective prosecution is a major problem within our judicial system’ as individuals who align with vested interests and commit egregious violations are rarely if ever prosecuted (in the future I will try to cover some such as this one and this one), whereas those who oppose them are often prosecuted for relatively minor violations.
This is a major issue with Medicare, where there are many examples of individuals committing egregious healthcare fraud which hurts many individuals, being given a pass for years, if not decades. Conversely, individuals in the integrative medical field frequently find themselves exposed to costly (and potentially career-destroying) audits for minor paperwork errors.
Because of what they have seen happen to others, every single integrative practitioner I know refuses to take Medicare (with the exclusion of one who designed their practice for Medicare and does not offer many other vital services to patients) because they cannot afford to take on the risk that receiving Medicare entails, which makes many vital aspects of health care unavailable to those who lack wealth. I listened to Fleming’s account of his crime (which could certainly be biased), and from that, I do not believe his offense in any way justified suspending his license, but again this illustrates why it is so challenging to take Medicare patientsas a provider who bucks the system.
Secondly, any physician who speaks out against medical orthodoxies (e.g., vaccines, using repurposed drugs to treat COVID-19) takes on an immense risk. They frequently have to worry about being fired from their place of employment, being blacklisted for future employment (this also happens to other whistleblowers, such as those within the pharmaceutical industry), losing their medical licenses, losing their board certifications, and in some cases, being targeted with physical violence. I have observed this throughout my entire career, and have found most of the well-intentioned physicians who challenge medical orthodoxies do so covertly rather than overtly (much of my success during my medical training came from identifying these individuals, who are everywhere, and them graciously offering their support to me).
In most cases, this results in physicians who speak out against prevailing orthodoxies being those at or near retirement because they can afford to be professionally dismantled (I highly respect Pierre Kory because he is an exception to this rule who, for some reason, was compelled to speak out and bear the risk that it entails at the prime of his career). In addition to physicians near retirement, the other demographic who frequently speak out are those who were already blacklisted for something else (e.g., Paul Marik), and thus have much less to lose by speaking out. While I feel that what happened to Fleming was unfortunate, it was also a blessing for the vaccine safety movement as he was a uniquely qualified expert to assess this issue (M.D., J.D., Ph.D., Cardiologist, journal editor, and having an extensive background in inflammation and blood clots).
I am in complete agreement with Dr. Burnett here.
I am also in complete agreement with Dr. Burnett here.
I sincerely hope this final Tweet serves to effectively illustrate many of the points I have shared throughout this series, and I sincerely thank Dr. Burnett for candidly revealing his internal thought process (some of which I even agree with). I also must thank him for a relatively fair fact-check (compare it to this one Kirsch recently reviewed) and for not attempting to debunk or attack aspects of my argument, which fall completely outside his knowledge base (e.g., the discussion on colloidal stability and microclotting).
Conclusion
One of the most challenging things about the entire COVID-19 debate is that those who oppose the narrative often encounter an experience akin to having one hand tied behind their back. Most of the evidence that should have been produced to settle questions pertaining to the safety and efficacy of the COVID-19 vaccines was never made available; rather we are just expected to assume that they must be safe because vaccines are infallible.
Nonetheless, because the COVID-19 vaccines are so unsafe and ineffective, data that demonstrates their shortcomings still continually emerges. In each case, that evidence is ignored or censored and whatever nonetheless gets through is deemed to be of insufficient quality. For example, in the recent New Zealand court case, the doctors insisted there was “no evidence” of the parent’s concerns, thereby repeating one of the most common failures in critical thinking we encounter in this era—that evidence one party deems insufficient is equivalent to “no evidence” existing.
I agree with John, and believe his comment synopsizes many of the shortfalls within our current educational system and demonstrates how doctors often apply the same algorithmic approach they are trained to practice medicine with to many other aspects of their lives.
Many are understandably upset with Dr. Burnett’s unwillingness to evaluate the evidence for views opposing his own, and have published pieces attacking him. I am reluctant to do so because I believe his ideas and not his character should be attacked. More importantly, I frequently meet physicians like Dr. Burnett who are caught up in the mass formation psychosis of the new “progressive” medical orthodoxy, and I have dealt with many far more antagonistic and closed-minded individuals.
If however, I am mistaken, and Dr. Burnett or any of his peers are genuinely interested in examining the evidence questioning the COVID-19 vaccine safety, I would highly advise they listen to Senator Ron Johnson’s recent roundtable discussion on the vaccines. This presentation provides the most concise summary I have seen thus far of the totality of evidence questioning the orthodoxy’s narrative.
In this series, I have attempted to make the case that critical thinking has been replaced with a pseudo-education that gives the appearance of intelligence but in reality creates standardized cognitive patterns which are programmed to arrive at conclusions supporting the vested interests which fund that education. On that point, one of the most common standardized patterns you observe is an algorithm that seeks to rapidly identify “authoritative sources” and then string them together until a configuration can be arrived at which defends the status quo (e.g., consider how often Burnett focused on the source rather than its evidence).
In a recent article, I detailed how creating compromised “impartial” authoritative sources is a cornerstone of all propaganda and that all industries default to this approach because it is frequently cheaper for them to create the perception that they are acting in good faith than it is to conduct their business in a manner the public would want to support.
In this series, I hope I have been able to establish how the educational system must be structured to support this technique. Going forward, I do not wish to engage in additional fact checks or debates over who is right, as this is a time-consuming process and it is quite likely that any future articles will be made redundant by the content within this series (as the flaws in how we teach critical thinking are unlikely to change in the near future). However, at the same time, I do feel obligated to maintain the accuracy of my work and will update the articles as errors are sent my way.
As I conclude, I want to highlight how many lies can be packaged into a simple series of widely held, but largely unchallenged assumptions. Since the public at large has very strong opinions on these assumptions, countless highly motivated researchers dug up much of the evidence necessary to disprove these orthodoxies (thus enabling me to be able to produce pieces like this), and the interest is present for the public to learn about it (hence why you want to read it).
Sadly, COVID-19 is by no means the first time that this has happened, and I can think of many other critical medical topics which were inaccurately portrayed at the behest of pharmaceutical interests, and for the most part those lies have remained unchallenged. Those other stories comprise a key aspect of the “Forgotten Side of Medicine” and it is my hope that as this project moves forward, you will help me to make it possible to reveal more of them.
Lastly, I wanted to thank everyone for your dedicated support. Today, I reached 25,000 subscribers, which is something I previously thought would never happen regardless of how long or how hard I worked here. I know that many of you have been going out of your way to share this Substack with others, and I am both profoundly grateful and deeply humbled by your support. It is my hope that I can continue to produce content here that adequately reciprocates what each of you has done for me.

The person who fact-checked you, Aditi Gangal, is a science major with no background in medicine or history and she did not even debunk any of the central points of your smallpox vacine article (which was excellent).
She is also the author of fact checks such as this:
"Fact Check: Can groundnut water tighten the vagina?"
https://www.thip.media/health-news-fact-check/fact-check-can-groundnut-water-tighten-the-vagina/37559/
Aditi meant peanut water. At this point I tend to reflexively take the opposite side on whatever Aditi opines, so I briefly considered taking a look into peanut water, but then decided to let this issue slide into obscurity and live in peace.
This is the only doctor I've found on Substack distributing information to us all for free. I've contacted most of the others and asked them if they could pause their earnings and freely distribute information for free until our war is over. NO WAY!! They won't have it. Thank you Midwestern Doc. You are a rare one. I will be promoting you on my Substack.